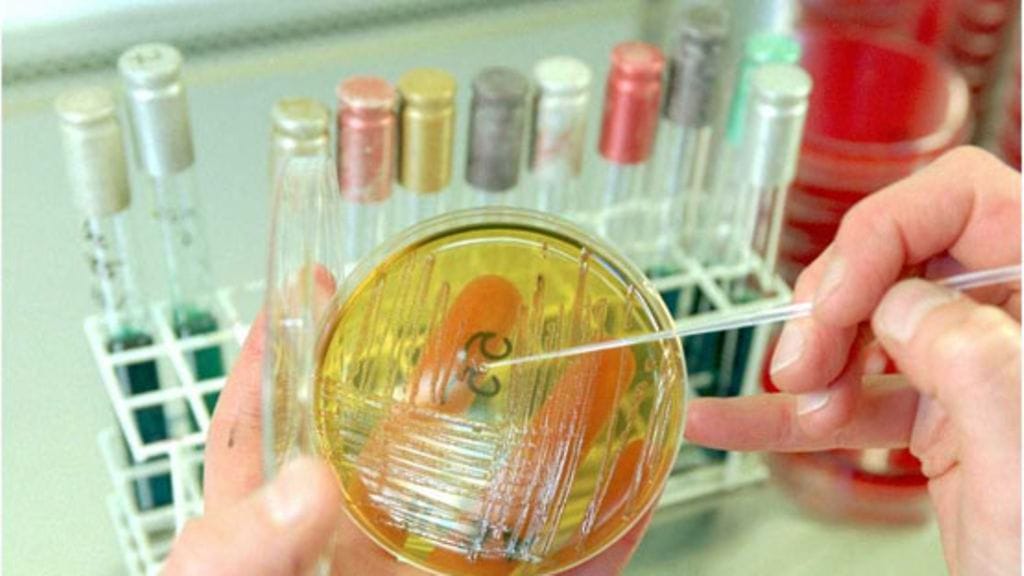

Yhdysvalloissa ainakin 13 ihmistä on kuollut syötyään pilaantuneita cantaloupe-meloneita. Maan terveysviranomaisten mukaan melonit oli kasvatettu Coloradossa tilalla, jonka tuotteista otetuista näytteistä on löytynyt listeriabakteeria.
Kuolleiden lisäksi yli 70 ihmistä on sairastunut syötyään pilaantuneita meloneita. Kuolleita ja sairastuneita on ollut ympäri Yhdysvaltoja. Sairaustapauksia alkoi ilmetä 31. heinäkuuta jälkeen.
Bakteerilöydös tehtiin jo aiemmin tässä kuussa, jolloin coloradolaisen tilan meloneista tehtiin takaisinkutsu. Hedelmiä oli ehditty lähettää ainakin 17 osavaltioon heinäkuun lopun ja syyskuun alun välillä.
Listeria voi aiheuttaa listerioosin, joka on erityisen vaarallinen vanhuksille ja raskaana oleville.
(MTV3 - STT - AFP - Reuters)
Listeria lisääntyy vaikka jääkaapissa - pese likainen hedelmä ennen leikkaamista